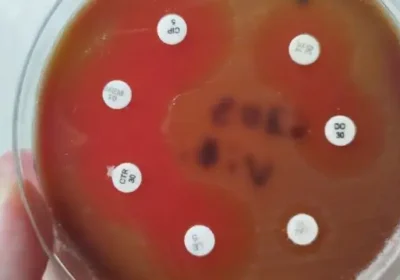

Бактерии в устната кухина може да предизвикват инфаркт

Учени са открили, че скрита бактериална инфекция може да е замесена в развитието на миокарден инфаркт. В ново проучване, публикувано в Journal of the American Heart Association, специалисти са анализирали проби от атеросклеротични плаки от 217 пациенти със съдови проблеми. Резултатите показват, че почти половината от пробите съдържат ДНК от viridans streptococci – това са бактерии, които обикновено живеят в […]
Read more